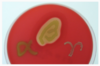

What is the gram staining process?
Gram staining:
1. Crystal violet
2. Iodine fixes the crystal violet to the peptidoglycan
3. Decolorizer like acetone, rinses off any unbound crystal violet and disintegrates the lipids of the cell membranes
4. Safranin red counterstain turns the gram-negative bacteria reddish pink

_ bacteria turn purple during staining due to their thick, mesh-like peptidoglycan cell wall
Gram-positive bacteria turn purple during staining due to their thick, mesh-like peptidoglycan cell wall
* The cell wall is cross linked which allows it to pick up the crystal violet stain and resist rinsing by acetone
Because gram-positive bacteria have no _ , the cross-linking in their _ is the last line of defense against osmotic stress
Because gram-positive bacteria have no outer membrane , the cross-linking in their cell wall is the last line of defense against osmotic stress
Beta-lactam antibiotics target gram-positive bacteria by binding to _ which inhibits peptidoglycan cross-linking and decreases cell wall stability
Beta-lactam antibiotics target gram-positive bacteria by binding to penicillin-binding proteins (PBPs) which inhibits peptidoglycan cross-linking and decreases cell wall stability
* Bacteria die from osmolysis
The peptidoglycan cell wall is covalently linked to _ , a long anionic polymer made of glycerol and phosphate repeats
The peptidoglycan cell wall is covalently linked to teichoic acid , a long anionic polymer made of glycerol and phosphate repeats
* Also lipoteichoic acids are the same thing but are linked to the head groups of membrane lipids
Teichoic acid and lipoteichoic acids give the bacterial cell a _ charge
Teichoic acid and lipoteichoic acids give the bacterial cell a negative charge
Only _ bacteria can make spores
Only gram-positive bacteria can make spores

Capsules can help the bacteria to resist _ and _
Capsules can help the bacteria to resist opsonization and phagocytosis
_ are the structures at the tops of the pili which form bonds with cell surface molecules
Fimbriae are the structures at the tops of the pili which form bonds with cell surface molecules
_ are a polysaccharide coating made of glycocalyx that is secreted by some gram-positive bacteria
Biofilms are a polysaccharide coating made of glycocalyx that is secreted by some gram-positive bacteria
* Mediates adherence to a surface
* Protection from antibiotics and immune response
_ are polypeptides that get secreted from gram-positive or gram-negative bacteria and harm the host by altering the host’s cell structure or function
Exotoxins are polypeptides that get secreted from gram-positive or gram-negative bacteria and harm the host by altering the host’s cell structure or function
_ are components of gram-negative bacterial outer membrane or cell walls
Endotoxins are components of gram-negative bacterial outer membrane or cell walls
_ is the capability of some gram-positive bacteria to invade host cells and live inside the phagosome or escape the phagosome; they replicate intracellularly and escape immune surveillance
Intracellular invasion is the capability of some gram-positive bacteria to invade host cells and live inside the phagosome or escape the phagosome; they replicate intracellularly and escape immune surveillance
_ converts fibrinogen to an insoluble fibrin capsule that then surrounds microorganisms and limits immune cell access to them
Coagulase converts fibrinogen to an insoluble fibrin capsule that then surrounds microorganisms and limits immune cell access to them
_ are lipids and proteins that can lyse RBCs by destroying their cell membrane
Hemolysins are lipids and proteins that can lyse RBCs by destroying their cell membrane
_ are enzymes that facilitate spread throughout the host’s tissues and include hyaluronidase, DNase, collagenase, lipase, elastase, and streptokinase
Spreading factors are enzymes that facilitate spread throughout the host’s tissues and include hyaluronidase, DNase, collagenase, lipase, elastase, and streptokinase
_ are powerful exotoxins that initiate the stimulation of the immune response by tightly binding the MHC class II molecules to T-cell receptors on antigen-presenting cells
Superantigens are powerful exotoxins that initiate the stimulation of the immune response by tightly binding the MHC class II molecules to T-cell receptors on antigen-presenting cells
* They can induce antigen-independent T cell activation and proinflammatory cytokines
* This is referred to as a cytokine storm
The two most likely modes of antibiotic resistance are _ and _
The two most likely modes of antibiotic resistance are conjugation and transduction
* Spontaneous mutation is rare

transduction shown
_ enzyme gives some gram-positive bacteria the ability to inactivate penicillin and its derivatives
Beta-lactamase enzyme gives some gram-positive bacteria the ability to inactivate penicillin and its derivatives
* Beta-lactamase cleaves the beta-lactam ring of beta-lactam antibiotics
Streptococcus pneumoniae also has resistance to beta-lactam because it has unique _ encoded in the genome sequence
Streptococcus pneumoniae also has resistance to beta-lactam because it has unique mutated penicillin-binding proteins encoded in the genome sequence
* This decreases the drug’s affinity for the bacteria
_ accounts for about 40% of all nosocomial (hospital-acquired) Staph aureus infections in the US
MRSA accounts for about 40% of all nosocomial (hospital-acquired) Staph aureus infections in the US
* Vancomycin had been a common drug to treat antibiotic-resistant strains like this but now resistant strains are increasing
_ produces yellow pigment on trypticase soy agar
Staph aureus produces yellow pigment on trypticase soy agar
The _ test can differentiate gram-positive cocci by their ability to catabolize hydrogen peroxide into wtaer and oxygen
The catalase test can differentiate gram-positive cocci by their ability to catabolize hydrogen peroxide into wtaer and oxygen
* This is important to differentiate between staphylococcus (+) from streptococcus (-)

Coagulase is a unique enzyme to _ and a positive test indicates that the bacteria can produce coagulase, which creates an insoluble fibrin capsule around the microorganism
Coagulase is a unique enzyme to S aureus and a positive test indicates that the bacteria can produce coagulase, which creates an insoluble fibrin capsule around the microorganism